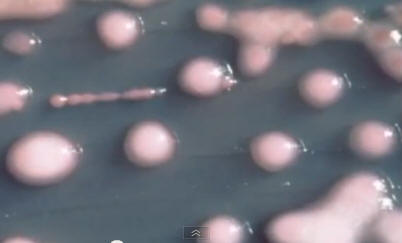

valokuva avoimista lähteistä
valokuva avoimista lähteistä
Amerikkalaiset lääkärit antavat hälytyksen sairaaloissa ja klinikoilla tappava “superbakteeri” leviää ympäri maata. 50% sen tartunnan saaneet ihmiset kuolevat, sitä vastaan tehdyt anti-biotikot ovat voimattomia. Bacillus on jo lempinimeltään “Nightmare bakteerit”, ja sen virallinen nimi C-R-E. Infektiotapaukset tallennettu 42x toteaa.
Yhdysvallat






